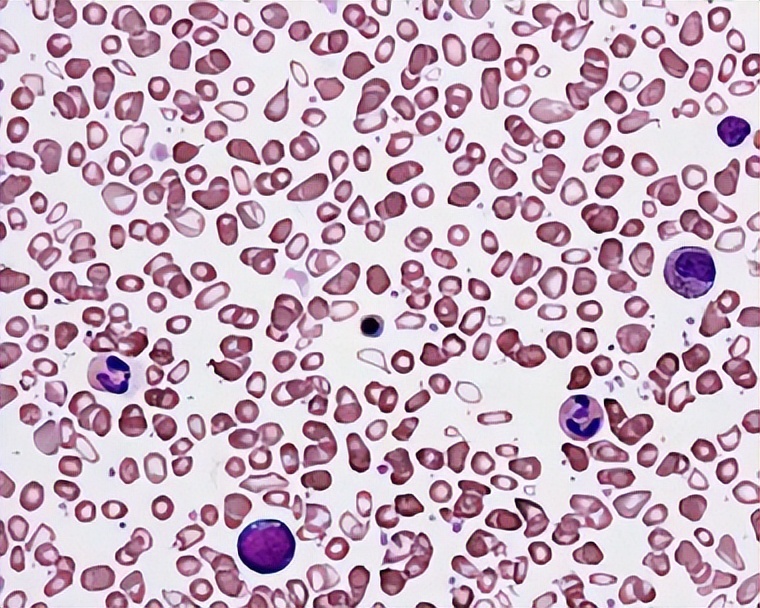
原发性血小板增多症的中医治疗,血小板增多症治疗最佳方法

血小板增多症是一种骨髓增生性疾病,其特征为出血或有出血倾向、血栓形成、外周血液中血小板的数量持续明显增多;血小板的数量多,功能不正常,这是由于骨髓巨核细胞过度增殖所致。
血小板增多症分为原发性血小板增多症和继发性血小板增多症
原发性血小板增多症是一种起源于造血干细胞的骨髓增殖性肿瘤性疾病,以骨髓中巨核细胞增殖旺盛、外周血血小板计数明显升高为特点。该病常伴发血栓形成、出血和脾肿大,具有向骨髓纤维化、骨髓增生异常综合征或急性白血病转化的风险。
继发性血小板增多症是指继发于其他疾病的一种常见的引起血小板增多的疾病,比如临床中常见的脾切除术后脾萎缩、脾栓塞,这些都会引起血小板增多。还有一部分是由常见的慢性肿瘤,急性和慢性失血之后以及慢性感染,以及各方面因素导致的。还有一部分包括免疫系统疾病,这些都可能会导致继发性血小板增多症。
血小板增多症起病缓慢、临床表现轻重不一,约有20%的患者,尤其是年轻人,一般无明显症状。有些患者往往是在体检中发现血小板的增高而来就诊,还有一部分患者是在出现心脑血栓事件之后才发现血小板升高。
西医治疗血小板增多症的常规方法,一是降低血小板,药物包括羟基脲和干扰素,但羟基脲的副作用以及干扰素的不耐受,使部分患者望而却步;二是预防血栓,常规使用阿司匹林,不但容易导致出血,而且可能出现阿司匹林抵抗。
中医根据原发性血小板增多症临床症状,将其归于“血瘀证”“积聚”“血证”范畴。根据中医临床辩证论治的思路,可以分为气滞血瘀、阴虚血瘀和血热妄行。

中医诊断原发性血小板增多症常见三种类型:
(1)气滞血瘀型:
证候 :胁下痞块、胀多于痛、痛有定处或拒按,舌质暗,脉沉涩。
证候分析 :气机阻滞,脉络不和,气血郁滞,积而成块,故胁下痞块,固定不移,气滞血阻,血行不畅,故胀多于痛。脉沉主病在里、脉涩,舌质紫暗主血瘀。
(2)阴虚血瘀型:
证候 :五心烦热,口干咽燥,多梦或不寐,心悸健忘,腰酸膝软,胁下痞块固定不移,隐隐作痛,面色紫暗,舌质红紫,脉弦细数。
证候分析 :肾水亏则阴血不足,虚火上炎故五心烦热,口干咽燥;心肾不交则多梦不寐,心悸健忘;腰为肾之府,肾虚则腰膝酸软;舌质红、脉细数、为阴虚内热之征。阴液亏损,血行不畅而瘀滞,故面色紫暗,舌质红紫,血瘀于胁下,脉络不通,故胁下痞块,隐隐作痛。

(3)血热妄行型:
证候 :五心烦热,口干咽燥,腰膝酸软,少寐多梦,心悸,便血,尿血或皮下瘀斑,或齿龈出血、咳血等,舌质红,脉细数。
证候分析 :肾阴不足,内热由生故腰膝酸软,五心烦热,口干咽燥。水不济火,心火亢盛则不寐多梦,心悸。热迫血妄行,血不循经故出血,热伤阳络血外溢,故皮下瘀斑等。热伤阴络血内溢,故便血、尿血等。脉细数,舌质红,为阴虚内热之症。西医诊断标准1.起病缓慢,轻者仅感乏力,重者有出血或血栓症状。

中医治疗思路与优势:
1. 活血化瘀,贯穿始终
活血化瘀药物可以消除髓血瘀滞,通畅血脉,有助于气血和畅,预防疾病后期向骨髓纤维化或急性白血病转化。此法可用于疾病任何阶段,瘀象轻微时适量选加活血之品,如红花、桃仁、丹参、川芎、赤芍等;若瘀象显著及因瘀而合并中风、胸痹、脉痹时,可酌情加大活血药量甚或加用破血之品,如三棱、莪术、水蛭等。活血、破血药物可耗伤正气,需配合益气扶正药物同用,如人参、黄芪、山药、白术等。此外,“气为血之帅,血为气之母”,活血散结与理气药物同用方可事半功倍,可辨证选用枳实、枳壳、香附、川楝子、乌药、元胡等药物行气以活血。
2.防栓防变,常备不懈
本病为克隆性疾病,血小板异常增高,存在发生血栓和转化为血液系统恶性肿瘤的风险,所以防栓防变至关重要。中医的治疗优势在于对整体机能的调理,通过四诊合参,辨明寒热虚实,阴阳表里,灵活运用化瘀消癥、行气活血、益气通络等方法,使气血和畅、阴平阳秘,以求未病先防、已病防变之功。临证之时活血行气药物对预防血栓不可或缺。现代药理研究表明,很多中草药具有防癌抗癌功效,例如:白花蛇舌草、黄药子、半边莲等,我们在辨证论治的基础上可以酌情使用。

3. 中药扶正固本
提高人体免疫功能以抗毒去邪,抑制病态细胞恶性增殖,提高患者生存质量。在疾病相对稳定阶段及骨髓明显受抑时适用,滋肾填精,常用中药有:二地、女贞子、石斛等;适时尚可益气养血,选用黄芪、太子参、西洋参、鸡血藤等。
4.辨证而治,治疗更有针对性
根据血小板增多症的5种类型:气滞血瘀型、肝脾血瘀型、气虚血瘀型、阴虚血瘀型、血热妄行型辩证治疗。
跟大家介绍一下我自己:吕妍,来自中国中医科学院西苑医院,血液科,副主任医师,硕士。擅长中西医结合治疗血液系统疾病:原发性血小板增多症、真性红细胞增多症、再生障碍性贫血、骨髓增生异常综合征、急性髓系白血病、免疫性血小板减少等。
本期内容就分享到这里,如果你对内容有疑问,请在评论区留言。欢迎大家关注我。如果喜欢今天的分享,请点赞收藏并将其分享给更多的朋友。

#血小板#